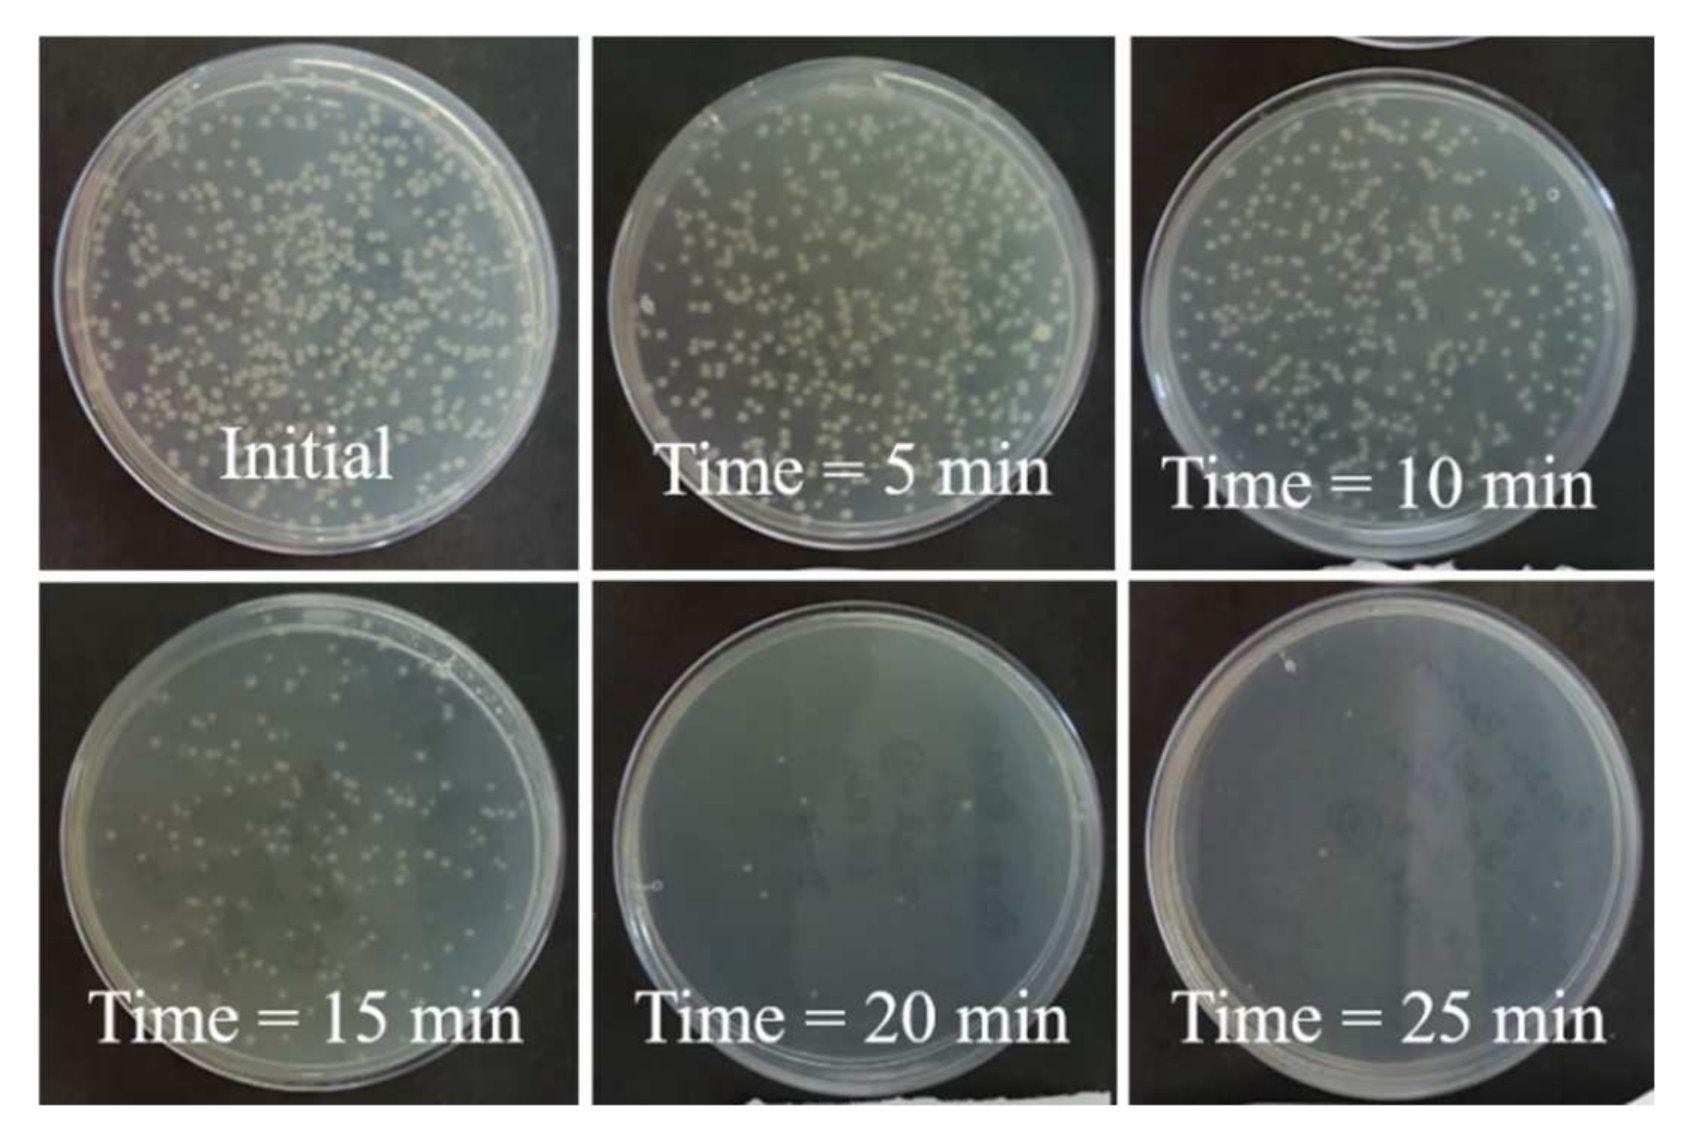

The Bacterial Disinfection of Water Using a Galloping Piezoelectric Wind Energy Harvester
Abstract
:1. Introduction
2. Materials and Methods
2.1. Analytical Modeling of the Galloping Piezoelectric Wind Energy Harvester
2.2. Experimental Setup and Bacterial Disinfection
3. Results and Discussion
3.1. Simulation and Experimental Results of the Piezoelectric Wind Energy Harvester
3.2. Electric Field Enhancement
3.3. Bacterial Disinfection
4. Conclusions
Author Contributions
Funding
Institutional Review Board Statement
Informed Consent Statement
Data Availability Statement
Acknowledgments
Conflicts of Interest
References
- Allaire, M.; Wu, H.; Lall, U. National trends in drinking water quality violations. Proc. Natl. Acad. Sci. USA 2018, 115, 2078–2083. [Google Scholar] [CrossRef] [PubMed] [Green Version]
- Bohn, P.W.; Elimelech, M.; Georgiadis, J.G.; Mariñas, B.J.; Mayes, A.M.; Mayes, A.M. Science and technology for water purification in the coming decades. Nanosci. Technol. A Collect. Rev. Nat. J. 2009, 452, 337–346. [Google Scholar] [CrossRef]
- Gleick, P.H. Dirty Water: Estimated Deaths from Water-Related Diseases 2000–2020; Pacific Institute for Studies in Development, Environment, and Security: Oakland, CA, USA, 2002; pp. 1–12. [Google Scholar]
- Prüss-Üstün, A.; Bos, R.; Gore, F.; Bartram, J. Safer Water, Better Health; World Health Organization: Geneva, Switzerland, 2008; p. 53. Available online: http://www.who.int/quantifying_ehimpacts/publications/saferwater/en/ (accessed on 16 July 2021).
- UNICEF; WHO. Progress on Household Drinking Water, Sanitation and Hygiene, 2000–2017; UNICEF: New York, NY, USA; WHO: Geneva, Switzerland, 2019; p. 140. Available online: https://washdata.org/sites/default/files/documents/reports/2019-07/jmp-2019-wash-households.pdf (accessed on 16 July 2021).
- Peter-Varbanets, M.; Zurbrügg, C.; Swartz, C.; Pronk, W. Decentralized systems for potable water and the potential of membrane technology. Water Res. 2009, 43, 245–265. [Google Scholar] [CrossRef] [PubMed]
- Chalmers, T.C.; Angelillo, I.F. Chlorination, chlorination by-products, and cancer: A meta-analysis. Am. J. Public Health 1992, 82, 955–963. [Google Scholar]
- Tian, C.; Liu, R.; Liu, H.; Qu, J. Disinfection by-products formation and precursors transformation during chlorination and chloramination of highly-polluted source water: Significance of ammonia. Water Res. 2013, 47, 5901–5910. [Google Scholar] [CrossRef] [PubMed]
- Deborde, M.; von Gunten, U. Reactions of chlorine with inorganic and organic compounds during water treatment-Kinetics and mechanisms: A critical review. Water Res. 2008, 42, 13–51. [Google Scholar] [CrossRef] [PubMed]
- Goswami, K.P.; Pugazhenthi, G. Credibility of polymeric and ceramic membrane filtration in the removal of bacteria and virus from water: A review. J. Environ. Manag. 2020, 268, 110583. [Google Scholar] [CrossRef]
- Deng, L.; Ngo, H.H.; Guo, W.; Zhang, H. Pre-coagulation coupled with sponge-membrane filtration for organic matter removal and membrane fouling control during drinking water treatment. Water Res. 2019, 157, 155–166. [Google Scholar] [CrossRef]
- Kim, I.; Tanaka, H. Photodegradation characteristics of PPCPs in water with UV treatment. Environ. Int. 2009, 35, 793–802. [Google Scholar] [CrossRef]
- Zhang, T.; Hu, Y.; Jiang, L.; Yao, S.; Lin, K.; Zhou, Y.; Cui, C. Removal of antibiotic resistance genes and control of horizontal transfer risk by UV, chlorination and UV/chlorination treatments of drinking water. Chem. Eng. J. 2019, 358, 589–597. [Google Scholar] [CrossRef]
- Chang, Y.; Kwan, P.; Pierson, G. Dynamic Energy Consumption of Advanced Water and Wastewater Treatment Technologies; Awwa Research Foundation: Denver, CO, USA, 2006. [Google Scholar]
- Schoenbach, K.H.; Joshi, R.P.; Stark, R.H.; Dobbs, F.C.; Beebe, S.J. Bacterial decontamination of liquids with pulsed electric fields. IEEE Trans. Dielectr. Electr. Insul. 2000, 7, 637–645. [Google Scholar] [CrossRef]
- Peng, P.; Cheng, Y.; Song, H.; Zhang, T.; Deng, S.; Anderson, E.; Addy, M.; Zhu, X.; Liu, S.; Hatzenbeller, R.; et al. Bacterial inactivation of liquid food and water using high-intensity alternate electric field. J. Food Process. Eng. 2017, 40, e12504. [Google Scholar] [CrossRef]
- Singh, R.K.; Babu, V.; Philip, L.; Ramanujam, S. Disinfection of water using pulsed power technique: Effect of system parameters and kinetic study. Chem. Eng. J. 2016, 284, 1184–1195. [Google Scholar] [CrossRef]
- Zhou, J.; Wang, T.; Yu, C.; Xie, X. Locally enhanced electric field treatment (LEEFT) for water disinfection. Front. Environ. Sci. Eng. 2020, 14, 78. [Google Scholar] [CrossRef]
- Pudasaini, S.; Perera, A.T.K.; Ahmed, S.S.U.; Chong, Y.B.; Ng, S.H.; Yang, C. An electroporation device with microbead-enhanced electric field for bacterial inactivation. Inventions 2020, 5, 2. [Google Scholar] [CrossRef] [Green Version]
- Huo, Z.-Y.; Li, G.-Q.; Yu, T.; Feng, C.; Lu, Y.; Wu, Y.-H.; Yu, C.; Xie, X.; Hu, H.-Y. Cell Transport Prompts the Performance of Low-Voltage Electroporation for Cell Inactivation. Sci. Rep. 2018, 8, 15832. [Google Scholar] [CrossRef] [PubMed]
- Pudasaini, S.; Perera, A.T.K.; Das, D.; Ng, S.H.; Yang, C. Continuous flow microfluidic cell inactivation with the use of insulating micropillars for multiple electroporation zones. Electrophoresis 2019, 40, 2522–2529. [Google Scholar] [CrossRef]
- Zhou, J.; Yu, C.; Wang, T.; Xie, X. Development of nanowire-modified electrodes applied in the locally enhanced electric field treatment (LEEFT) for water disinfection. J. Mater. Chem. A 2020, 8, 12262–12277. [Google Scholar] [CrossRef]
- Zhou, J.; Wang, T.; Xie, X. Rationally designed tubular coaxial-electrode copper ionization cells (CECICs) harnessing non-uniform electric field for efficient water disinfection. Environ. Int. 2019, 128, 30–36. [Google Scholar] [CrossRef]
- Yu, Z.; Zeng, H.; Min, X.; Zhu, X. High-performance composite photocatalytic membrane based on titanium dioxide nanowire/graphene oxide for water treatment. J. Appl. Polym. Sci. 2020, 137, 2–14. [Google Scholar] [CrossRef]
- Zhou, J.; Wang, T.; Chen, W.; Lin, B.; Xie, X. Emerging investigator series: Locally enhanced electric field treatment (LEEFT) with nanowire-modified electrodes for water disinfection in pipes. Environ. Sci. Nano 2020, 7, 397–403. [Google Scholar] [CrossRef]
- Huo, Z.Y.; Liu, H.; Yu, C.; Wu, Y.H.; Hu, H.Y.; Xie, X. Elevating the stability of nanowire electrodes by thin polydopamine coating for low-voltage electroporation-disinfection of pathogens in water. Chem. Eng. J. 2019, 369, 1005–1013. [Google Scholar] [CrossRef]
- Liu, C.; Xie, X.; Zhao, W.; Yao, J.; Kong, D.; Boehm, A.B.; Cui, Y. Static electricity powered copper oxide nanowire microbicidal electroporation for water disinfection. Nano Lett. 2014, 14, 5603–5608. [Google Scholar] [CrossRef] [PubMed]
- Kumar, S.; Sharma, M.; Kumar, A.; Powar, S.; Vaish, R. Rapid bacterial disinfection using low frequency piezocatalysis effect. J. Ind. Eng. Chem. 2019, 77, 355–364. [Google Scholar] [CrossRef]
- Ding, W.; Zhou, J.; Cheng, J.; Wang, Z.; Guo, H.; Wu, C.; Xu, S.; Wu, Z.; Xie, X.; Wang, Z.L. TriboPump: A Low-Cost, Hand-Powered Water Disinfection System. Adv. Energy Mater. 2019, 9, 1–8. [Google Scholar] [CrossRef]
- Huo, Z.Y.; Kim, Y.-J.; Suh, I.-Y.; Lee, D.-M.; Lee, J.H.; Du, Y.; Wang, S.; Yoon, H.-J.; Kim, S.-W. Triboelectrification induced self-powered microbial disinfection using nanowire-enhanced localized electric field. Nat. Commun. 2021, 12, 3693. [Google Scholar] [CrossRef] [PubMed]
- Hu, G.; Tse, K.T.; Wei, M.; Naseer, R.; Abdelkefi, A.; Kwok, K.C.S. Experimental investigation on the efficiency of circular cylinder-based wind energy harvester with different rod-shaped attachments. Appl. Energy 2018, 226, 682–689. [Google Scholar] [CrossRef]
- Wang, J.; Zhou, S.; Zhang, Z.; Yurchenko, D. High-performance piezoelectric wind energy harvester with Y-shaped attachments. Energy Convers. Manag. 2019, 181, 645–652. [Google Scholar] [CrossRef]
- Zhao, L.; Tang, L.; Yang, Y. Comparison of modeling methods and parametric study for a piezoelectric wind energy harvester. Smart Mater. Struct. 2013, 22, 125003. [Google Scholar] [CrossRef]
- Erturk, A. Electromechanical Modeling of Piezoelectric Energy Harvesters. Doctoral Dissertation, Virginia Polytechnic Institute and State University, Blacksburg, VA, USA, 2009; p. 291. Available online: http://hdl.handle.net/10919/29927 (accessed on 21 July 2021).
- Barrero-Gil, A.; Sanz-Andrés, A.; Roura, M. Transverse galloping at low Reynolds numbers. J. Fluids Struct. 2009, 25, 1236–1242. [Google Scholar] [CrossRef] [Green Version]
- Parkinson, G. Phenomena and modelling of flow-induced vibrations of bluff bodies. Prog. Aerosp. Sci. 1989, 26, 169–224. [Google Scholar] [CrossRef]
- Yang, Y.; Zhao, L.; Tang, L. Comparative study of tip cross-sections for efficient galloping energy harvesting. Appl. Phys. Lett. 2013, 102, 064105. [Google Scholar] [CrossRef]
- Zhou, C.F.; Zou, H.X.; Wei, K.X.; Liu, J.G. Enhanced performance of piezoelectric wind energy harvester by a curved plate. Smart Mater. Struct. 2019, 28, 125022. [Google Scholar] [CrossRef]
- Ding, L.; Yang, L.; Yang, Z.; Zhang, L.; Wu, C.; Yan, B. Performance improvement of aeroelastic energy harvesters with two symmetrical fin-shaped rods. J. Wind Eng. Ind. Aerodyn. 2019, 196, 104051. [Google Scholar] [CrossRef]
- Wang, T.; Chen, H.; Yu, C.; Xie, X. Rapid determination of the electroporation threshold for bacteria inactivation using a lab-on-a-chip platform. Environ. Int. 2019, 132, 105040. [Google Scholar] [CrossRef] [PubMed]
- Wagner, C. Investigations on silver sulfide. J. Chem. Phys. 1953, 21, 1819–1827. [Google Scholar] [CrossRef]
- Xu, C.H.; Woo, C.H.; Shi, S.Q. Formation of CuO nanowires on Cu foil. Chem. Phys. Lett. 2004, 399, 62–66. [Google Scholar] [CrossRef]
- Huo, Z.Y.; Hai Liu, H.; Wang, W.-L.; Wang, Y.-H.; Wu, Y.-H.; Xie, X.; Hu, H.-Y. Low-voltage alternating current powered polydopamine-protected copper phosphide nanowire for electroporation-disinfection in water. J. Mater. Chem. A 2019, 7, 7347–7354. [Google Scholar] [CrossRef]
- Kotnik, T.; Frey, W.; Sack, M.; Meglič, S.H.; Peterka, M.; Miklavčič, D. Electroporation-based applications in biotechnology. Trends Biotechnol. 2015, 33, 480–488. [Google Scholar] [CrossRef]
- Xie, X.; Zhou, J.; Wang, T. Locally Enhanced Electric Field Treatment (LEEFT) promotes the performance of ozonation for bacteria inactivation by disrupting the cell membrane. Environ. Sci. Technol. 2020, 54, 14017–14025. [Google Scholar] [CrossRef]
- Zhou, J.; Yang, F.; Huang, Y.; Ding, W.; Xie, X. Smartphone-powered efficient water disinfection at the point of use. npj Clean Water 2020, 3, 40. [Google Scholar] [CrossRef]

| Properties | Value |
|---|---|
| Mass of cantilever beam | 2.54 g |
| Mass of bluff body | 2.52 g |
| Mass of curve-shaped attachments | 3.45 g |
| Effective mass, | 7.5 g |
| Effective damping, | 0.0059 N/(m/s) |
| Effective stiffness, | 6.8359 N/m |
| Open circuit natural frequency, | 4.8211 Hz |
| Short circuit natural frequency, | 4.8141 Hz |
| Capacitance of the piezoelectric patch, | 1.3574 × 10−8 F |
| Electromechanical coupling coefficient, | 2.24 × 10−5 N/V |
| Damping ratio, | 0.013 |
| No. | Reference | Bluff Body | Piezoelectric Beam | Wind Velocity (m/s) | Output RMS Voltage (V) | |||
|---|---|---|---|---|---|---|---|---|
| Shape | Windward Width (mm) | Height (mm) | Material | Dimensions in mm (Length × Width × Thickness) | ||||
| 1. | Zhao et al. [37] | Square | 40 | 150 | Aluminum | 150 × 30 × 0.6 | 8 | 30 |
| 2. | Zhou et al. [38] | Curved plate | 35 | 100 | Tin bronze | 180 × 10 × 0.8 | 5 | 5 |
| 3. | Gang et al. [31] | Cylindrical body with circular attachments | 48 | 240 | Stainless Steel | 200 × 26 × 0.95 | 8 | 19 |
| 4. | Ding et al. [39] | Cylindrical body with fin-shaped attachments | 30 | 150 | Stainless Steel | 120 × 15 × 0.5 | 7 | 14 |
| 5. | Present work | Cylindrical body with curve-shaped attachments | 32 | 120 | Aluminum | 200 × 25 × 0.6 | 4 | 25 |
| No. | Reference | Study | Applied Voltage (Electrical Parameters) | Portable | Self-Powered | Flow/Steady Mode | Capacity | Log Inactivation Efficiency |
|---|---|---|---|---|---|---|---|---|
| 1. | Xie et al. [45] | LEEFT with ozonation | 1.2 VDC | × | × | Flow | 4 mL/min, 2.2 HRT (min) | 6-log |
| 2. | Zhou et al. [46] | Smart phone powered LEEFT | 2 VDC | Yes | × | Flow | 10 mL/min, 0.88 HRT (min) | 3-log |
| ~1.8 VDC | 5 mL/min, 1.77 HRT (min) | 6-log | ||||||
| ~1.4 | 2 mL/min, 4.43 HRT (min) | |||||||
| 3. | Ding et al. [29] | Tribo pump | IRMS = 80 µm R = several kΩ | Yes | Yes | Flow | 2–2.5 HRT (min) | 6-log |
| 4. | Zhou et al. [25] | LEEFT in pipes | 0.5 VDC | × | × | Flow | >1 mL/min >8.86 HRT (min) | 1-log |
| 1 VDC | 1 mL/min, 8.86 HRT (min) | 6-log | ||||||
| 2 VDC | 1 mL/min, 8.86 HRT (min) | |||||||
| 5. | Present work | Piezoelectric wind energy harvester for LEEFT | 0.1 V | Yes | Yes | Steady | 0.8 mL/min | 2.33-log |
Publisher’s Note: MDPI stays neutral with regard to jurisdictional claims in published maps and institutional affiliations. |
© 2022 by the authors. Licensee MDPI, Basel, Switzerland. This article is an open access article distributed under the terms and conditions of the Creative Commons Attribution (CC BY) license (https://creativecommons.org/licenses/by/4.0/).
Share and Cite
Poudel, P.; Sharma, S.; Ansari, M.N.M.; Kumar, P.; Ibrahim, S.M.; Vaish, R.; Kumar, R.; Thomas, P. The Bacterial Disinfection of Water Using a Galloping Piezoelectric Wind Energy Harvester. Energies 2022, 15, 6133. https://doi.org/10.3390/en15176133
Poudel P, Sharma S, Ansari MNM, Kumar P, Ibrahim SM, Vaish R, Kumar R, Thomas P. The Bacterial Disinfection of Water Using a Galloping Piezoelectric Wind Energy Harvester. Energies. 2022; 15(17):6133. https://doi.org/10.3390/en15176133
Chicago/Turabian StylePoudel, Prakash, Saurav Sharma, Mohamed Nainar Mohamed Ansari, Pushpendra Kumar, Sobhy M. Ibrahim, Rahul Vaish, Rajeev Kumar, and Paramanandam Thomas. 2022. "The Bacterial Disinfection of Water Using a Galloping Piezoelectric Wind Energy Harvester" Energies 15, no. 17: 6133. https://doi.org/10.3390/en15176133
APA StylePoudel, P., Sharma, S., Ansari, M. N. M., Kumar, P., Ibrahim, S. M., Vaish, R., Kumar, R., & Thomas, P. (2022). The Bacterial Disinfection of Water Using a Galloping Piezoelectric Wind Energy Harvester. Energies, 15(17), 6133. https://doi.org/10.3390/en15176133

